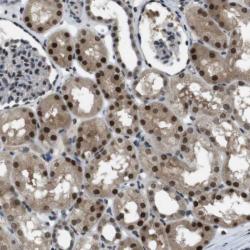

Antibody data
- Antibody Data
- Antigen structure
- References [6]
- Comments [0]
- Validations
- Immunohistochemistry [1]
Submit
Validation data
Reference
Comment
Report error
- Product number
- sc-7866 - Provider product page

- Provider
- Santa Cruz Biotechnology
- Proper citation
- Santa Cruz Biotechnology Cat#sc-7866, RRID:AB_638562
- Product name
- Anti-MAF
- Antibody type
- Polyclonal
- Antigen
- Recombinant full-length protein
- Reactivity
- Human
- Host
- Rabbit
Submitted references The tumor suppressor gene Trp53 protects the mouse lens against posterior subcapsular cataracts and the BMP receptor Acvr1 acts as a tumor suppressor in the lens.
The aryl hydrocarbon receptor interacts with c-Maf to promote the differentiation of type 1 regulatory T cells induced by IL-27.
MAPK-activated protein kinase 2 differentially regulates plasmodium falciparum glycosylphosphatidylinositol-induced production of tumor necrosis factor-{alpha} and interleukin-12 in macrophages.
Foxa2 and MafA regulate islet-specific glucose-6-phosphatase catalytic subunit-related protein gene expression.
Development of macrophages with altered actin organization in the absence of MafB.
Truncation of C-mip (Tc-mip), a new proximal signaling protein, induces c-maf Th2 transcription factor and cytoskeleton reorganization.
Wiley LA, Rajagopal R, Dattilo LK, Beebe DC
Disease models & mechanisms 2011 Jul;4(4):484-95
Disease models & mechanisms 2011 Jul;4(4):484-95
The aryl hydrocarbon receptor interacts with c-Maf to promote the differentiation of type 1 regulatory T cells induced by IL-27.
Apetoh L, Quintana FJ, Pot C, Joller N, Xiao S, Kumar D, Burns EJ, Sherr DH, Weiner HL, Kuchroo VK
Nature immunology 2010 Sep;11(9):854-61
Nature immunology 2010 Sep;11(9):854-61
MAPK-activated protein kinase 2 differentially regulates plasmodium falciparum glycosylphosphatidylinositol-induced production of tumor necrosis factor-{alpha} and interleukin-12 in macrophages.
Zhu J, Wu X, Goel S, Gowda NM, Kumar S, Krishnegowda G, Mishra G, Weinberg R, Li G, Gaestel M, Muta T, Gowda DC
The Journal of biological chemistry 2009 Jun 5;284(23):15750-61
The Journal of biological chemistry 2009 Jun 5;284(23):15750-61
Foxa2 and MafA regulate islet-specific glucose-6-phosphatase catalytic subunit-related protein gene expression.
Martin CC, Flemming BP, Wang Y, Oeser JK, O'Brien RM
Journal of molecular endocrinology 2008 Nov;41(5):315-28
Journal of molecular endocrinology 2008 Nov;41(5):315-28
Development of macrophages with altered actin organization in the absence of MafB.
Aziz A, Vanhille L, Mohideen P, Kelly LM, Otto C, Bakri Y, Mossadegh N, Sarrazin S, Sieweke MH
Molecular and cellular biology 2006 Sep;26(18):6808-18
Molecular and cellular biology 2006 Sep;26(18):6808-18
Truncation of C-mip (Tc-mip), a new proximal signaling protein, induces c-maf Th2 transcription factor and cytoskeleton reorganization.
Grimbert P, Valanciute A, Audard V, Pawlak A, Le gouvelo S, Lang P, Niaudet P, Bensman A, Guellaƫn G, Sahali D
The Journal of experimental medicine 2003 Sep 1;198(5):797-807
The Journal of experimental medicine 2003 Sep 1;198(5):797-807
No comments: Submit comment
Supportive validation
- Submitted by
- per
- Main image
- Experimental details
- Immunohistochemical staining of human kidney shows strong nuclear positivity in cells of tubules.
- Validation comment
- Staining pattern partly consistent with experimental and/or bioinformatic data.